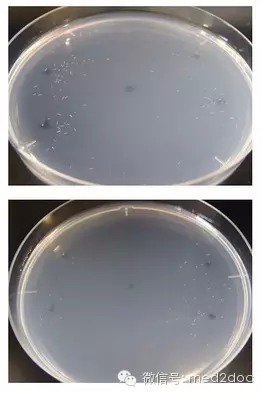

| 导读 癌病患者带有特殊气味,嗅觉不亚于犬类的线虫对此有反应,研究发现它们喜欢接近癌症患者尿液,对健康者的尿液则避之不及。 日本九州大学等研究小组在11日的美国科学杂志PLOS ONE网络版上公布,已证实能够通过体长1毫米的线虫对人体尿液气味的反应精确判断是否患有癌症。检查费用每次100日元(约合人民币5.2日元)至数百日元不等,约1个半小时后可得出诊断结果。有望到2019年左右投入实际运用。 A Highly Accurate Inclusive Cancer Screening Test Using Caenorhabditis elegans Scent Detection  由于还可能发现以往的检查中无法查出的早期癌症,这项成果有望提高受诊率并实现早期治疗。 团队成员之一、神经学助教广津崇亮介绍说:“把在家中采集的1滴尿液送到检查机构,就可查到是否患有癌症。同时也能降低诊疗费。”  线虫是生活在土壤及水中的微小生物,繁殖方式简单。研究小组指出,癌病患者带有特殊气味,而嗅觉不亚于犬类的线虫对此气味有反应。该小组之后验证了线虫喜欢接近癌症患者尿液而对健康人群尿液避之不及的习性。 在242人尿液反应测试中,24例癌症患者中23人结果呈阳性,218名健康人士中207人呈阴性,癌症确诊准确率高达95.8%,高于同时进行的血液肿瘤标志物检查准确率。 此外,5例癌症患者在尿检时尚未知晓病情,研究组认为这种方法还能发现早期癌症。 现阶段尚无法检出癌症种类,只对特定癌症产生反应的线虫的培育已取得成功,有望早期检出胃癌、食管癌、前列腺癌和胰腺癌,未来有望投入实际运用。 秀丽隐杆线虫  秀丽隐杆线虫是一种无毒无害、可以独立生存的线虫 。其个体小,成体仅1.5mm长,为雌雄同体(hermaphrodites),雄性个体仅占群体的0.2%,可自体受精或双性生殖;在20℃下平均生活史为3.5天,平均繁殖力为300-350个;但若与雄虫交配,可产生多达1400个以上的后代。2003年2月,在哥伦比亚号航天飞机的爆炸事故中,部分秀丽隠杆线虫的标本存活下来,立即成为新闻的焦点。 狗能检测甲状腺癌 最近,来自美国阿肯色大学的研究人员在第97届内分泌学会年会上报告,他们发现经过嗅觉训练的狗能够通过尿液样本精确检测出病人是否患有甲状腺癌。  狗的管理者先将已知的甲状腺癌病人尿液放在名叫Frankie狗的面前,让其进行嗅闻,并给与其奖励:若为癌症病人样本,Frankie会卧倒表示;若为良性样本,Frankie会转身离开。最终结果证明,Frankie正确识别了34例病人中30人的尿液样本,正确率高达86.7%,而对真阴性样本的识别正确率达到89.5%,这意味着Frankie检测10次有9次能够识别出良性样本。 |
 /3
/3 